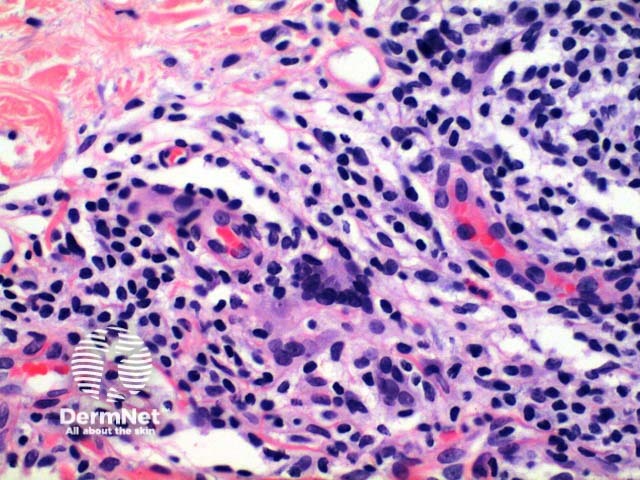
Figure 4

Main menu
Common skin conditions
NEWS
Join DermNet PRO
Read more
Quick links
Author: Dr Ben Tallon, Dermatologist/Dermatopathologist, Tauranga, New Zealand, 2011.
Scanning power view of lichen nitidus identifies a focal dermal inflammatory infiltrate enclosed within collarettes of epidermal acanthosis (Figures 1 and 2). Focal erosion of the epidermis in figure 1 indicates excoriation. Higher power view identifies a well circumscribed lymphohistiocytic infiltrate with multinucleated giant cells (Figures 3 and 4).

Figure 1

Figure 2

Figure 3
Figure 4
Micropapular sarcoidosis: The inflammatory infiltrate is also seen focally within the papillary dermis, but is predominantly histiocytic forming non caseating epithelioid granulomas.
Lichen scrofulosorum: The non caseating granulomas are typically centred on the hair follicles or sweat ducts.
Papular granuloma annulare: Shows localized changes, but otherwise retains the typical infiltrate and collagen changes of granuloma annulare.